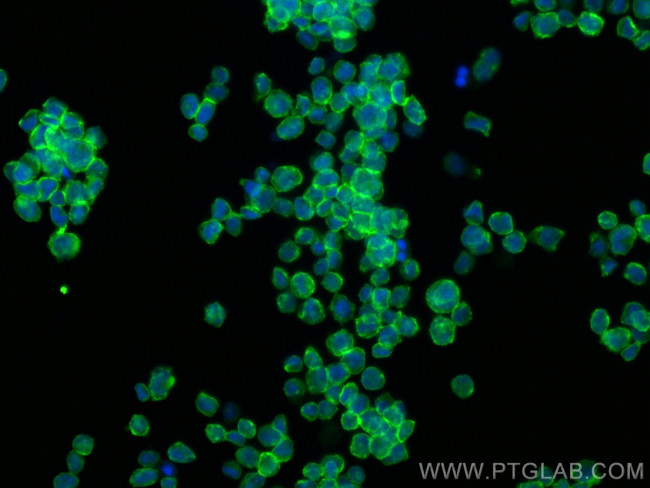
SIRP Alpha Antibody in Immunocytochemistry (ICC/IF)

Search
Proteintech
SIRP Alpha Polyclonal Antibody
{{$productOrderCtrl.translations['antibody.pdp.commerceCard.promotion.promotions']}}
{{$productOrderCtrl.translations['antibody.pdp.commerceCard.promotion.viewpromo']}}
{{$productOrderCtrl.translations['antibody.pdp.commerceCard.promotion.promocode']}}: {{promo.promoCode}} {{promo.promoTitle}} {{promo.promoDescription}}. {{$productOrderCtrl.translations['antibody.pdp.commerceCard.promotion.learnmore']}}
产品信息
31485-1-AP
种属反应
宿主/亚型
分类
类型
抗原
偶联物
形式
浓度
规格
纯化类型
保存液
内含物
保存条件
运输条件
靶标信息
SIRP alpha (CD172a, signal-regulatory protein alpha) is a receptor-type transmembrane glycoprotein expressed on cells of myeloid origin, including granulocytes, dendritic cells (DCs), macrophages, mast cells and hematopoietic stem cells. SIRP alpha acts as a substrate for several activated tyrosine kinases, including EGFR, PDGFR, src and insulin receptor and is involved in the negative regulation of receptor tyrosine kinase-coupled signaling pathways. The ligand binding of SIRP alpha to integrin-associated protein CD47 results in tyrosine kinase phosphorylation of immunoreceptor tyrosine-based inhibitory motifs (ITIMs) within the cytoplasmic region of SIRP alpha, which mediates the recruitment and activation of the tyrosine phosphatases SHP-1 and SHP-2. Ligation of SIRP alpha with CD47 has been demonstrated in several regulatory processes, including the inhibition of host cell phagocytosis by macrophages and the bi-directional activation of T cells and DCs. SIRP alpha has regulatory effects on cellular responses induced by serum, growth factors, insulin, oncogenes, growth hormones and cell adhesion, and plays a general role in different physiological and pathological processes. Cancer cells highly express CD47, which activates SIRP alpha and inhibits macrophage-mediated destruction of cancerous cell growth.
仅用于科研。不用于诊断过程。未经明确授权不得转售。
篇参考文献 (0)
生物信息学
蛋白别名: Bit; Brain Ig-like molecule with tyrosine-based activation motifs; Brain immunoglobulin like protein with tyrosine - based activation motifs; brain immunological-like with tyrosine-based motifs; brain-immunoglobulin-like molecule with tyrosine-based activation motifs; CD172 alpha; CD172 antigen-like family member A; CD172a; Inhibitory receptor SHPS-1; Macrophage fusion receptor; Macrophage membrane protein MFP150; mSIRP-alpha1; MyD-1 antigen; p84; Protein tyrosine phosphatase non-receptor type substrate 1 (SHP substrate 1); protein tyrosine phosphatase, non-receptor type substrate 1; Protein tyrosine phosphatase, non-receptor type substrate 1 (SHP substrate 1); SHP substrate 1; Signal-regulatory protein alpha-1; Signal-regulatory protein alpha-2; Signal-regulatory protein alpha-3; Sirp-alpha-1; Sirp-alpha-2; Sirp-alpha-3; SIRP-alpha1; SIRPalpha; SIRPalpha2; tyrosine phosphatase SHP substrate 1; Tyrosine-protein phosphatase non-receptor type substrate 1; unnamed protein product
基因别名: AI835480; BIT; CD172A; MFR; MYD-1; MYD1; P84; PTPNS1; SHP-1; SHPS-1; SHPS1; SIRP; SIRPA
UniProt ID: (Human) P78324, (Rat) P97710, (Mouse) P97797
Entrez Gene ID: (Human) 140885, (Rat) 25528, (Mouse) 19261